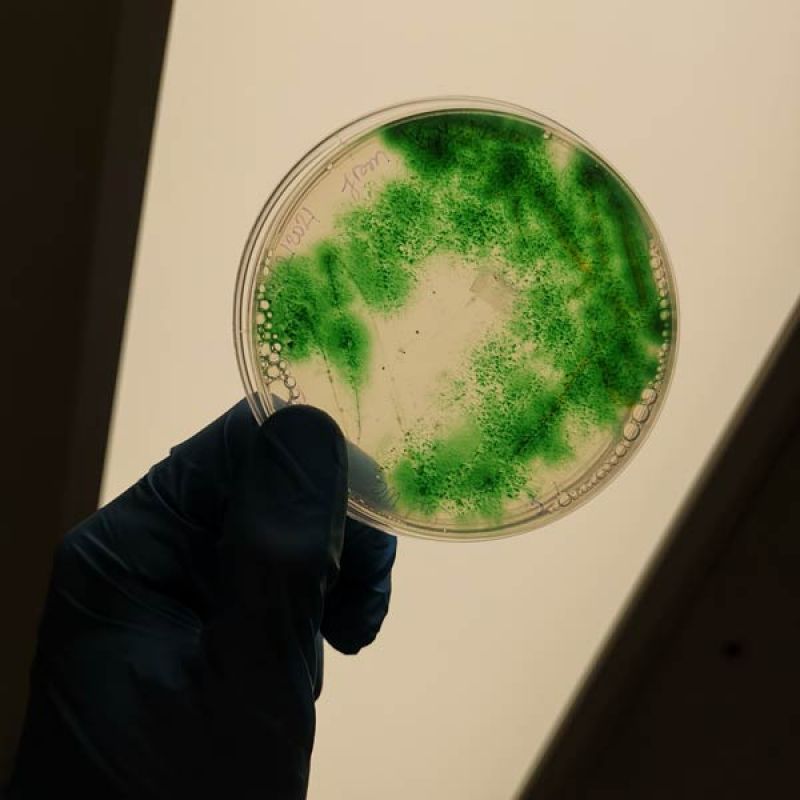
Person with lab gloves holding a Cyanobacterial Bloom Plate up to a light

Microbial and Molecular Diversity
The Neilan Laboratory is a world leader in the molecular biology and biochemistry of toxic cyanobacteria (blue-green algae) and other microbes of environmental and biomedical significance.
This research is both fundamental and applied, with outcomes including improvements to water quality monitoring and management, as well as the production of novel compounds of biomedical value. Focus areas include the discovery, characterisation and manipulation of natural product pathways, including those for cyanobacterial toxins as well as UV-blocking compounds and food preservatives.
Gallery

Symbiotic cyanobacteria in ascidians (a class of sessile filter-feeding invertebrates).

Cyanobacteria bloom at Ross Wallbridge Reserve, Raymond Terrace.

Cyanobacteria growing on an agar plate.

Aedes vigilax (saltmarsh mosquito), an aggressive biter and vector of Ross River virus.

Cissus sterculiifolia for the study of microbial endophytes.

Leaves, stems and roots of Cissus sterculiifolia for the study of microbial endophytes.

Scanning electron microscope image of symbiotic microbes

Stromatolite reef, formed by cyanobacteria, at Shark Bay in Western Australia.

xScanning electron microscope image of symbiotic microbes.

Cyanobacteria bloom at Ross Wallbridge Reserve, Raymond Terrace.

Stromatolite reef, formed by cyanobacteria, at Shark Bay in Western Australia.
Cyanobacteria growing on an agar plate.
The University of Newcastle acknowledges the traditional custodians of the lands within our footprint areas: Awabakal, Darkinjung, Biripai, Worimi, Wonnarua, and Eora Nations. We also pay respect to the wisdom of our Elders past and present.


